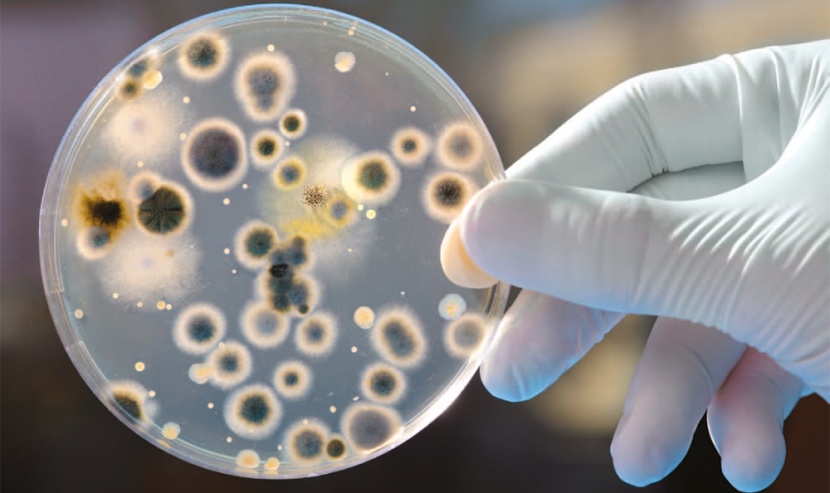
دراسة.. تحذر من خطر ارتفاع عدد الوفيات الناتجة عن الجراثيم متعددة المقاومة

دراسة.. تحذر من خطر ارتفاع عدد الوفيات الناتجة عن الجراثيم متعددة المقاومة
حذرت دراسة ألمانية حديثة من خطر ارتفاع حالات الوفاة الناتجة عن الإصابة بالجراثيم متعددة المقاومة بشكل كبير، إذا لم يتم تعديل مسار استخدام المضادات الحيوية.
وأجرت مستشفى "شاريته" الألمانية بالعاصمة برلين هذه الدراسة بتكليف من كتلة حزب الخضر في البرلمان الألماني "بوندستاج"، ونشرتها صحيفة "برلينر تسايتونج" الألمانية في عددها الصادر اليوم الثلاثاء.
ونقلت الصحيفة عما جاء في الدراسة: "أن الزيادة العالمية للجراثيم المقاومة للمضادات الحيوية يندرج ضمن أكبر المخاطر على صحة الإنسان".
وحذر الباحثون الذين أجروا هذه الدراسة من ارتفاع عدد حالات الوفاة الناتجة عن الإصابة بجراثيم متعددة المقاومة من 700 ألف سنويا حاليا إلى عشرة ملايين حتى عام 2050، إذا لم يتم اتخاذ إجراءات مضادة لمواجهة الأمر.
وتوقع الباحثون بالنسبة لقارة أوروبا ارتفاع عدد حالات الوفاة من 23 ألف حالة حاليا إلى 400 ألف حالة.
وأشاروا إلى أن عدد الوفيات الناتجة عن الجراثيم متعددة المقاومة سيزيد بذلك عن الوفيات الناتجة عن الإصابة بالسرطان.